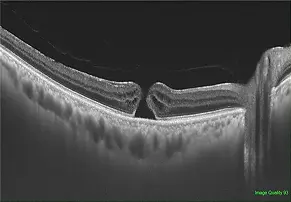
Photo

Curated and labeled datasets
IDHea’s structured, multi-level labeled data provides an opportunity to define baseline ocular health and study early disease patterns, and drive advancements in AI-powered diagnostics.
IDHea uses a tiered pricing model based on the level of labeling and analysis included with each dataset.